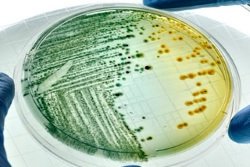

Нормальные микроорганизмы кишечника – это колонии бактерий, заселяющие просвет нижних отделов пищеварительного тракта и поверхность слизистой оболочки. Они нужны для качественного переваривания химуса (пищевого комка), обмена веществ и активации местной защиты в отношении инфекционных возбудителей, а также токсических продуктов.
Нормальная микрофлора кишечника
– это баланс различных микробов нижних отделов пищеварительной системы, то есть их количественное и качественное соотношение, необходимое для поддержания биохимического, метаболического, иммунологического равновесия организма и сохранения здоровья человека.
Функции микрофлоры кишечника
Представители кишечной микрофлоры
Нормы содержания бактерий в кишечнике
Полезные бактерии кишечника
Как проверить нормальную микрофлору?
Низкое содержание нормальной микрофлоры – что делать?
Источники
Функции микрофлоры кишечника
- Защитная функция. Нормальная микрофлора обладает выраженным противодействием в отношении патогенных и условно-патогенных микроорганизмов. Полезные бактерии препятствуют заселению кишечника иными, не свойственными ему инфекционными возбудителями. В случае снижения количества нормальной микрофлоры, начинают размножаться потенциально опасные микроорганизмы. Развиваются гнойно-воспалительные процессы, происходит бактериальное заражение крови (септицемия). Поэтому важно не допускать уменьшения количества нормальной микрофлоры.
- Пищеварительная функция. Кишечная микрофлора участвует в ферментации белков, жиров, высокомолекулярных углеводов. Полезные бактерии разрушают под действием воды основную массу клетчатки и остатки химуса, поддерживают в кишечнике необходимый уровень кислотности (рН). Микрофлора инактивирует пищеварительные ферменты (щелочную фосфатазу, энтерокиназу), участвует в образовании продуктов распада белков (фенола, индола, скатола) и стимулируют перистальтику. Также микроорганизмы пищеварительного тракта регулируют метаболизм холестерина и желчных кислот. Способствуют трансформации билирубина (желчного пигмента) в стеркобилин и уробилин. Полезные бактерии играют важную роль на конечных этапах превращения холестерина. Из него образуется копростерин, который не всасывается в толстой кишке и выводится с калом. Нормофлора способна снижать выработку печенью желчных кислот и контролировать нормальный уровень холестерина в организме.
- Синтетическая (метаболическая) функция. Полезные бактерии пищеварительного тракта вырабатывают витамины (С, К, Н, РР, Е, группы В) и незаменимые аминокислоты. Кишечная микрофлора способствует лучшему усвоению железа и кальция, поэтому препятствует развитию таких заболеваний как анемия и рахит. За счет действия полезных бактерий происходит активное всасывание витаминов (D3, В12 и фолиевой кислоты), регулирующих систему кроветворения. Метаболическая функция кишечной микрофлоры также проявляется в способности синтезировать ими антибиотикоподобные вещества (ацидофилин, лактоцидин, колицин и другие) и биологически активные соединения (гистамин, диметиламин, тирамин и т. д.), которые препятствуют росту и размножению патогенных микроорганизмов.
- Детоксикационная функция. Эта функция ассоциируется с возможностями кишечной микрофлоры сокращать количество и удалять с каловыми массами опасные токсические продукты: соли тяжелых металлов, нитриты, мутагены, ксенобиотики и другие. Вредные соединения не задерживаются в тканях организма. Полезные бактерии предотвращают их токсическое воздействие.
- Иммунная функция. Нормофлора кишечника стимулирует синтез иммуноглобулинов – особых белков, повышающих защитные силы организма в отношении опасных инфекций. Также полезные бактерии содействуют созреванию системы фагоцитирующих клеток (неспецифический иммунитет), способных к поглощению и уничтожению патогенных микробов (см. подробнее о влиянии микрофлоры кишечника на иммунитет).
Медицинские специалисты подчеркивают важность нормального содержания представителей полезной микрофлоры кишечника для поддержания здоровья. В норме в кишечнике человека должно находиться около 100 триллионов бактерий, которые играют ключевую роль в пищеварении, синтезе витаминов и защите от патогенных микроорганизмов. Основные группы таких бактерий включают лактобактерии, бифидобактерии и кишечные палочки. Врачи отмечают, что баланс этих микроорганизмов может варьироваться в зависимости от возраста, рациона питания и общего состояния здоровья. Например, у новорожденных преобладают бифидобактерии, тогда как у взрослых наблюдается более разнообразный состав. Нормальное содержание полезной микрофлоры способствует укреплению иммунной системы и снижению риска развития различных заболеваний, таких как дисбактериоз и кишечные инфекции. Поэтому поддержание здорового баланса микробиоты является важной задачей для каждого человека.

Представители кишечной микрофлоры
| Микроорганизмы в кишечнике человека | Наименование бактерий |
|---|---|
| Нормальные |
|
| Условно-патогенные |
|
| Патогенные |
|
Вся микрофлора кишечника подразделяется на:
- нормальную (основную);
- условно-патогенную;
- патогенную.
Среди всех представителей встречаются анаэробы и аэробы. Отличие их друг от друга заключается в особенностях существования и жизнедеятельности. Аэробы – это микроорганизмы, способные жить и размножаться только в условиях постоянного доступа кислорода. Представители другой группы делятся на 2 вида: облигатные (строгие) и факультативные (условные) анаэробы. И те, и другие, получают энергию для своего существования при отсутствии доступа кислорода. Для облигатных анаэробов он губителен, а для факультативных – нет, то есть микроорганизмы могут существовать в его присутствии.
Советуем почитать: Вопросы и факты о кишечной микрофлоре
Нормальные микроорганизмы
К ним относятся грамположительные (бифидобактерии, лактобактерии, эубактерии, пептострептококки) и грамотрицательные (бактероиды, фузобактерии, вейлонеллы) анаэробы. Такое название их связано с фамилией датского бактериолога – Грама. Он разработал специальный метод окрашивания мазков с использованием анилинового красителя, йода и спирта. При микроскопии часть бактерий имеет сине-фиолетовый цвет и относится к грамположительным. Другие микроорганизмы обесцвечиваются. Для лучшей визуализации этих бактерий применяется контрастный краситель (фуксин), который окрашивает их в розовый цвет. Это грамотрицательные микроорганизмы.
Все представители данной группы являются строгими анаэробами. Они составляют основу всей кишечной микрофлоры (92-95%). Полезные бактерии вырабатывают антибиотикоподобные вещества, помогающие вытеснить из среды обитания возбудителей опасных инфекций. Также нормальные микроорганизмы создают зону «закисления» (рН=4,0-5,0) внутри кишечника и образуют защитную пленку на поверхности его слизистой оболочки. Таким образом, формируется барьер, препятствующий колонизации посторонних бактерий, попавших извне. Полезные микроорганизмы регулируют баланс условно-патогенной флоры, предотвращая ее избыточный рост. Участвуют в синтезе витаминов.
Представители нормальной микрофлоры кишечника играют ключевую роль в поддержании здоровья человека. Многие специалисты подчеркивают, что баланс этих микроорганизмов влияет на пищеварение, иммунную систему и даже настроение. Нормы содержания полезных бактерий варьируются, но их недостаток может привести к различным проблемам, таким как дисбактериоз, аллергии и нарушения обмена веществ. Люди отмечают, что при соблюдении правильного питания, включающего ферментированные продукты, таких как йогурт и квашеная капуста, можно значительно улучшить состояние кишечной флоры. Кроме того, пробиотики и пребиотики становятся все более популярными, так как они способствуют восстановлению и поддержанию здорового баланса микробов. Важно помнить, что индивидуальные потребности могут различаться, и консультация с врачом поможет определить оптимальные меры для поддержания здоровья кишечника.

Условно-патогенные микроорганизмы
Основная статья: Условно-патогенная микрофлора кишечника
К ним относятся грамположительные (клостридии, стафилококки, стрептококки, бациллы) и грамотрицательные (эшерихии – кишечные палочки и другие представители семейства энтеробактерий: протей, клебсиелла, энтеробактер, цитробактер и т. д.) факультативные анаэробы.
Эти микроорганизмы являются условно-патогенными. То есть, при благополучии в организме их влияние только положительное, как и у нормальной микрофлоры. Воздействие неблагоприятных факторов приводит к их избыточному размножению и превращению в болезнетворных возбудителей. Развивается кишечный дисбактериоз с диареей, изменением характера стула (жидкий с примесью слизи, крови или гноя) и ухудшением общего самочувствия. Количественный рост условно-патогенной микрофлоры может быть связан с ослабленным иммунитетом, воспалительными заболеваниями пищеварительной системы, неправильным питанием и применением лекарственных препаратов (антибиотиков, гормонов, цитостатиков, анальгетиков и других средств).
Главный представитель энтеробактерий – это кишечная палочка с типичными биологическими свойствами. Она способна активировать синтез иммуноглобулинов. Специфические белки взаимодействуют с патогенными микроорганизмами из семейства энтеробактерий и препятствуют их проникновению в слизистую оболочку. Помимо этого кишечная палочка продуцирует вещества – колицины с антибактериальной активностью. То есть нормальные эшерихии способны тормозить рост и размножение гнилостных и патогенных микроорганизмов из семейства энтеробактерий – кишечной палочки с измененными биологическими свойствами (гемолизирующие штаммы), клебсиелл, протея и других. Эшерихии принимают участие в синтезе витамина К.
К условно-патогенной микрофлоре также относятся дрожжеподобные грибы рода Candida. Они редко обнаруживаются у здоровых детей и взрослых. Выявление их в кале, даже в небольшом количестве, должно сопровождаться клиническим обследованием пациента с целью исключения кандидоза (избыточного роста и размножения дрожжеподобных грибов). Особенно это актуально у детей младшего возраста и больных со сниженным иммунитетом.
Патогенные микроорганизмы
Основная статья: Патогенная микрофлора кишечника
Это бактерии, попадающие в пищеварительный тракт извне и вызывающие острые кишечные инфекции. Заражение патогенными микроорганизмами может произойти при употреблении в пищу загрязненных продуктов питания (овощи, фрукты и т. д.) и воды, при нарушении правил личной гигиены и контакте с больным. В норме в кишечнике не встречаются. К ним относятся патогенные возбудители опасных инфекций – дизентерии, сальмонеллеза, псевдотуберкулеза и других заболеваний. Наиболее частые представители этой группы – шигеллы, сальмонеллы, иерсинии и т. д. Некоторые возбудители (золотистый стафилококк, синегнойная палочка, нетипичная кишечная палочка) могут встречаться среди медицинского персонала (носители патогенного штамма) и в больничных учреждениях. Они вызывают серьезные госпитальные инфекции.
Все болезнетворные бактерии провоцируют развитие кишечного воспаления по типу энтерита или колита с расстройством стула (диарея, в кале слизь, кровь, гной) и развитием интоксикации организма. Полезная микрофлора угнетается.
Нормы содержания бактерий в кишечнике
Полезные бактерии
| Нормальные микроорганизмы | Дети до 1 года на грудном вскармливании
КОЕ/г |
Дети до 1 года на искусственном вскармливании
КОЕ/г |
Дети старше 1 года
КОЕ/г |
Взрослые
КОЕ/г |
|---|---|---|---|---|
| Бифидобактерии | 109–1010 | 108–1010 | 1010–1011 | 109–1010 |
| Лактобактерии | 106–107 | 107–108 | 107–108 | >109 |
| Эубактерии | 106–107 | >1010 | 109–1010 | 109–1010 |
| Пепто-стрептококки | <105 | >109 | 109–1010 | 109–1010 |
| Бактероиды | 107–108 | 108–109 | 109–1010 | 109–1010 |
| Фузобактерии | <106 | <106 | 108–109 | 108–109 |
| Вейлонеллы | <105 | >108 | 105–106 | 105–106 |
Советуем почитать: Подвздошная кишка: расположение, строение и функции
КОЕ/г – это количество колонии образующих единиц микробов в 1 грамме испражнений.
Условно-патогенные бактерии
| Условно-патогенные микроорганизмы | Дети до 1 года на грудном вскармливании
КОЕ/г |
Дети до 1 года на искусственном вскармливании
КОЕ/г |
Дети старше 1 года
КОЕ/г |
Взрослые
КОЕ/г |
|---|---|---|---|---|
| Кишечные палочки с типичными свойствами | 107–108 | 107–108 | 107–108 | 107–108 |
| Клостридии | 105–106 | 107–108 | <=105 | 106–107 |
| Стафилококки | 104–105 | 104–105 | <=104 | 103–104 |
| Стрептококки | 106–107 | 108–109 | 107–108 | 107–108 |
| Бациллы | 102–103 | 108–109 | <104 | <104 |
| Грибы рода Candida | отсутствуют | отсутствуют | <104 | <104 |
Полезные бактерии кишечника
Грамположительные строгие анаэробы:
- Бифидобактерии – представители основной микрофлоры, присутствуют в здоровом кишечнике на протяжении всей жизни. Занимают доминирующее положение среди других микроорганизмов. Бифидобактерии обеспечивают защиту организма от патогенных бактерий и препятствуют их попаданию в верхние отделы желудочно-кишечного тракта и другие внутренние органы. Особенно это актуально у детей на первом году жизни. Бифидобактерии продуцируют молочную и уксусную кислоты, способствующие хорошему усвоению кальция, железа и витамина D. Также эти полезные микроорганизмы синтезируют белки и аминокислоты, витамины (группы В, К, никотиновую, пантотеновую и фолиевую кислоты), стимулируют кишечный иммунитет. Бифидобактерии могут быть резистентны к некоторым противомикробным средствам: пенициллину, стрептомицину и рифампицину.
- Лактобактерии – палочковидные микроорганизмы. Присутствуют практически во всех отделах пищеварительной системы. Обладают антибактериальной активностью (выделяют спирт, лизоцим, лактоцидин и другие вещества) в отношении гнилостных и гноеродных микробов. Защищают слизистую оболочку кишечника. Резистентны к антибиотикам: пенициллину и ванкомицину. Лактобактерии могут выделяться из кишечника новорожденных уже в первые дни после рождения. У взрослых, придерживающихся строгой вегетарианской диеты, их количество больше нормы.
- Эубактерии – коккобациллы, то есть микроорганизмы с промежуточной формой (не палочковидной и не шарообразной). Редко встречаются у детей, находящихся на естественном вскармливании. Однако у малышей, питающихся смесями, выявляются довольно часто. Эубактерии участвуют в метаболизме холестерина (трансформация холестерола в копростанол) и желчных кислот.
- Пептострептококки – шаровидные микроорганизмы, относящиеся к нормальной микрофлоре кишечника. Редко встречаются у детей на грудном вскармливании. У малышей, питающихся смесями, определяются всегда. В результате генетических мутаций могут попадать в нехарактерные для них места обитания, вызывая тем самым инфекционное воспаление. Часто они высеваются при септицемии, остеомиелите, гнойном артрите, аппендиците и других абсцессах. Наряду с другими анаэробами, пептострептококки выявляются при гингивитах и пародонтозах.
Грамотрицательные строгие анаэробы:
- Бактероиды – полиморфные (имеющие разный размер и форму) палочки. Вместе с бифидобактериями заселяют кишечник новорожденных к 6–7 дню жизни. При грудном вскармливании бактероиды выявляются у 50% детей. При искусственном питании высеваются в большинстве случаев. Бактероиды принимают участие в пищеварении и расщеплении желчных кислот.
- Фузобактерии – полиморфные палочковидные микроорганизмы. Характерны для кишечной микрофлоры взрослых людей. Нередко высеваются из патологического материала при гнойных осложнениях различной локализации. Способны секретировать лейкотоксин (биологическое вещество с токсическим действием по отношению к лейкоцитам) и фактор агрегации тромбоцитов, ответственный за тромбоэмболии при тяжелой септицемии.
- Вейлонеллы – кокковые микроорганизмы. У детей, находящихся на грудном вскармливании, выявляются менее чем в 50% случаев. У малышей на искусственном питании смесями высеваются в высокой концентрации. Вейлонеллы способны к большой продукции газа. При их избыточном размножении эта отличительная черта может привести к диспепсическим расстройствам (метеоризму, отрыжке и диарее).
Советуем почитать: Что такое брыжейка кишечника, ее расположение и функции
Как проверить нормальную микрофлору?
Следует провести бактериологическое исследование кала путем посева на специальные питательные среды. Забор материала производят стерильным шпателем из последней порции испражнений. Нужный объем кала – 20 грамм. Материал для исследования помещают в стерильную посуду без консервантов. Необходимо учитывать тот факт, что микроорганизмы – анаэробы должны быть надежно защищены от действия кислорода с момента забора кала до его посева. Рекомендуется использовать пробирки, заполненные специальной газовой смесью (углекислый газ (5%) + водород (10%) + азот (85%)) и плотно притертой крышкой. От момента забора материала до начала бактериологического исследования должно пройти не больше 2 часов.
Читайте подробнее: Анализ кала на кишечную микрофлору
Этот анализ кала позволяет обнаружить широкий спектр микроорганизмов, высчитать их соотношение и диагностировать видимые расстройства – дисбактериоз. Для нарушений в составе кишечной микрофлоры характерно снижение доли полезных бактерий, повышение количества условно-патогенной флоры с изменением ее нормальных биологических свойств, а также появление болезнетворных возбудителей.
Низкое содержание нормальной микрофлоры – что делать?
Проводится коррекция дисбаланса микроорганизмов с помощью специальных препаратов:
- Пребиотики способствуют колонизации кишечника основной микрофлорой за счет избирательной стимуляции роста и метаболической активности одной или нескольких групп бактерий. Данные препараты не являются лекарственными средствами. К ним относятся не переваренные ингредиенты пищи, являющиеся субстратом для полезных бактерий и не подвергающиеся действию пищеварительных ферментов. Препараты: «Хилак форте», «Дюфалак» («Нормазе»), «Пантотенат кальция», «Лизоцим» и другие.
- Пробиотики – это живые микроорганизмы, нормализующие баланс кишечных бактерий и конкурирующие с условно-патогенной флорой. Благотворно влияют на здоровье человека. Они содержат полезные бифидобактерии, лактобактерии, молочнокислый стрептококк и т. д. Препараты: «Ацилакт», «Линекс», «Бактисубтил», «Энтерол», «Колибактерин», «Лактобактерин», «Бифидумбактерин», «Бификол», «Примадофилус» и другие.
- Иммуностимулирующие средства. Применяются для поддержания нормального микробиоценоза кишечника и повышения защитных сил организма. Препараты: «КИП», «Иммунал», «Эхинацея» и т. д.
- Лекарственные средства, регулирующие транзит кишечного содержимого. Используются для улучшения пищеварения и эвакуации пищи. Препараты: ферменты, витамины, спазмолитики, желчегонные и т. д.
Таким образом, нормальная микрофлора с ее специфическими функциями – защитной, обменной и иммуностимулирующей – определяет микробную экологию пищеварительного тракта и участвует в поддержании постоянства внутренней среды организма (гомеостазе).
https://youtu.be/LXuVUYKUelM
Источники
- Intestine Flora. Effect on the Host Metabolism M.H. Sarafian, … A. Hart, in The Microbiota in Gastrointestinal Pathophysiology, 2017
- Diversity of the Human Intestinal Microbial Flora Paul B. Eckburg,1,* Elisabeth M. Bik,2 Charles N. Bernstein,3 Elizabeth Purdom,4 Les Dethlefsen,2 Michael Sargent,3 Steven R. Gill,5 Karen E. Nelson,5 and David A. Relman1,2,6, Published in final edited form as: Science. 2005 Jun 10; 308(5728): 1635–1638.
- РОЛЬ МИКРОБИОТЫ КИШЕЧНИКА В ПОДДЕРЖАНИИ ГОМЕОСТАЗА ОРГАНИЗМА. Рылова Н.В., Жолинский А.В., Самойлов А.С. Журнал Современные проблемы науки и образования. – 2019. – № 6 Дата публикации 30.12.2019
- Кишечная микрофлора – один из факторов формирования здоровья человека Текст научной статьи по специальности «Фундаментальная медицина» Булатова Е.М. Богданова Н.М.
- Микробиом кишечника: от эталона нормы к патологии Текст научной статьи по специальности «Фундаментальная медицина» Шевелева Светлана Анатольевна Куваева Инна Борисовна Ефимочкина Наталья Рамазановна Маркова Юлия Михайловна Просянников Михаил Юрьевич. 2020
- Нарушение нормального состава кишечных бактерий: клиническое значение и вопросы терапии. Приложение РМЖ «Болезни Органов Пищеварения» №2 от 05.12.2008 стр. 41. Авторы: Яковенко Э.П. , Иванов А.Н. , Казарина А.В. , Маматходжаев Р.Х. , Похальская О.Ю. , Григорьева Ю.В. , Каграманова А.В. 1 , Попова Е.В. , Гиоева И.З. , Яковенко А.В. , Агафонова Н.А. , Прянишникова А.С.
- Юдина Ю.В., Корсунский А.А., Аминова А.И., Абдуллаева Г.Д., Продеус А.П. Микробиота кишечника как отдельная система организма. Доказательная гастроэнтерология. 2019;8(4):36‑43.
Вопрос-ответ
Какая должна быть микрофлора кишечника?
У здоровых лиц в кишечнике насчитывается более 500 видов микроорганизмов. Общая масса микрофлоры кишечника составляет от 1 до 3 кг. В разных отделах ЖКТ количество бактерий различно, большинство микроорганизмов локализованы в толстой кишке (около 1010–12 КОЕ/мл, что составляет 35–50% ее содержимого).
Какая микрофлора в норме?
Нормальная микрофлора влагалища включает: лактобактерии, бифидобактерии, бактероиды, пропионибактерии, порфиромонады, превотеллы, пептострептококки, коринеформные бактерии др. , в ней преобладают анаэробы. В норме соотношение анаэробы/аэробы равно 10: 1.
Сколько полезных бактерий в кишечнике?
Таким образом, у здоровых лиц в кишечнике насчитывается около 500 видов различных микроорганизмов, большую часть из которых составляют представители так называемой облигатной микрофлоры – бифидобактерии, лактобактерии, непатогенная кишечная палочка и др. На 92–95% микрофлора кишечника состоит из облигатных анаэробов.
Как оценить микрофлору кишечника?
Анализ Колонофлор проводится методом ПЦР, которая позволяет определить наличие и количество различных микроорганизмов в кишечнике. Для проведения анализа необходимо сдать образец кала, который затем отправляется в лабораторию для исследования. Результаты анализа будут доступны в течение нескольких дней.
Советы
СОВЕТ №1
Регулярно включайте в свой рацион продукты, богатые пробиотиками, такие как йогурт, кефир и ферментированные овощи. Эти продукты помогут поддерживать баланс нормальной микрофлоры кишечника.
СОВЕТ №2
Обратите внимание на потребление клетчатки, которая способствует росту полезных бактерий. Овощи, фрукты, цельнозерновые продукты и бобовые — отличные источники клетчатки.
СОВЕТ №3
Избегайте избыточного употребления антибиотиков без назначения врача, так как они могут негативно влиять на состав микрофлоры кишечника. Если антибиотики необходимы, обсудите с врачом возможность приема пробиотиков во время и после курса лечения.
СОВЕТ №4
Следите за своим состоянием и обращайте внимание на симптомы дисбаланса микрофлоры, такие как вздутие, запоры или диарея. При возникновении таких проблем проконсультируйтесь с врачом для получения рекомендаций по восстановлению нормальной микрофлоры.